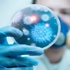
طرح أحدث عقار فرنسي لعلاج ''مرض الملوك''

أخرى من منوعات»
لا توجد صور











احمد عدنان نجم - انا جمهورية
20 يونيو 2014 12:10
5 أطعمة لا يجب وضعها في الفريزر
20 يونيو 2014 21:00
دراسة: الفيس بوك يحسن المزاج
20 يونيو 2014 20:06
أعراض عديدة للتسمم الغذائي
20 يونيو 2014 20:06 لا توجد صورشركة “غوغل” و “كوستكو” و “فيسبوك” أعلى نسبة أجور فى العالم
20 يونيو 2014 19:19 لا توجد صورفودافون تكشف عن وجود أسلاك سرية تسمح للحكومات بالتجسس على المس...
20 يونيو 2014 19:19 لا توجد صوراليابان تكشف عن أول روبوت يقرأ المشاعر البشرية
20 يونيو 2014 19:19 لا توجد صورأكواب ذكية تميز المشروبات وتعطيك معلومات عنه
20 يونيو 2014 19:19 لا توجد صورالشراكات، التمويل، والمحتوى: أبرز نقاشات خبراء ميكس ان منتور
20 يونيو 2014 19:19 لا توجد صور“مايكروسوفت موبايل” تعتزم الكشف عن “نوكيا إكس 2 8243 الثلاثاء ...
20 يونيو 2014 19:19 لا توجد صورغوغل تطرح تطبيق البريد الإلكتروني الرسمي لأندرويد في متجر غوغل...
20 يونيو 2014 19:19 لا توجد صورYo تطبيق جديد للنكز ينتشر كالنار في الهشيم
20 يونيو 2014 19:19
عائلات مختطفي الخليل تلجأ للشعوذة بعد فشل جيش الاحتلال
20 يونيو 2014 19:01 لا توجد صورفيسبوك يستعيد عافيته بعد انقطاع في الخدمة لمدة 30 دقيقة
20 يونيو 2014 18:21 لا توجد صورفيسبوك يتعطل 20 دقيقة والسبب مجهول
20 يونيو 2014 18:21
الشرطة: استمرار الإعتقالات في قضية مقتل الشاب رعد حصارمة من ال...
20 يونيو 2014 18:14
دراسة: الوفيات بسبب الإفراط فى المسكنات أكثر من الهيروين والكو...
20 يونيو 2014 17:09
أمازون توفر تطبيقات "أندرويد" لبلاك بيري
20 يونيو 2014 17:09
زهير الخويلدي - سيرورة التثقف وتبدل الأطوار الحضارية
20 يونيو 2014 16:03 لا توجد صورظهور حالات إصابة بفيروس الشيكونغونيا في ولايات أميركية
20 يونيو 2014 15:11 لا توجد صورعشر نساء لا ينساهن الرجال.. هل أنت منهن؟
20 يونيو 2014 14:14 لا توجد صورنصائح الشيف ريمو لتوفير وقتك في رمضان
20 يونيو 2014 13:19 لا توجد صورخلطة الزعفران وماء الورد لعلاج تساقط الشعر
20 يونيو 2014 13:19 لا توجد صورللمرأة الرياضية الشيكولاتة بالحليب أفضل من مشروبات الطاقة
20 يونيو 2014 13:19 لا توجد صورارتفاع نسب الإصابة بالسرطان بسبب العادات الخاطئة
20 يونيو 2014 13:19 لا توجد صورخدعوكِ فقالوا حقائب حمل الطفل تؤذي الظهر
20 يونيو 2014 13:19 لا توجد صوراهتمي بأناقة أطفالك الصغار في البيت
20 يونيو 2014 13:19 لا توجد صورنصائح لحفظ حليب الأم بطريقة سليمة
20 يونيو 2014 13:19 لا توجد صورنصائح صيفية للقضاء على «حب الشباب»
20 يونيو 2014 13:19 لا توجد صور«فيس بوك» تزود تطبيقها على أجهزة «آي باد» بمحتوى لعشاق الألعاب
20 يونيو 2014 11:13
طرح أحدث عقار فرنسي لعلاج ''مرض الملوك''
20 يونيو 2014 09:08
شخصية مولود الميزان رومانسية وما يميزه عن غيره من الأبراج كلام...
20 يونيو 2014 08:03 لا توجد صورالوقوف على أطراف الأصابع يقوي عضلات القدم
20 يونيو 2014 06:10 لا توجد صورالجلوس طويلا قد يتسبب في الإصابة بالسرطان !
20 يونيو 2014 06:10 لا توجد صورتناول الفراولة يخفض من ضغط الدم !
20 يونيو 2014 06:10 لا توجد صوراستشارات
20 يونيو 2014 04:13 لا توجد صور«عدوى الحمل» بين الصديقات.. تنافس أم غيرة؟
20 يونيو 2014 03:11 لا توجد صورجوز الهند.. ما هي حقيقة الادعاءات حول فوائده الصحية؟
20 يونيو 2014 03:11 لا توجد صورالجراثيم.. هل تساهم في علاج الحساسية للرضع؟
20 يونيو 2014 03:11
الصيف والأمراض
20 يونيو 2014 03:08 لا توجد صورمَنْ هم الأبطال؟ ومَنْ هم الحرامية؟
20 يونيو 2014 02:03 لا توجد صورسيّدة البرامج على كل الشاشات
20 يونيو 2014 02:03أخبار ساخنة من منوعات»
جديد من منوعات»
- هل من ترياقات صالحة لعكس مفاعيل الشيخوخة؟ ...
- السعودية تفتح التسجيل في أكبر فعالية أمن س...
- المؤرخ الجزائري: على من تقرأ زابورك يا...؟...
- أفضل طرق لعلاج الخوف والقلق
- نصائح لتناول الفول والطعمية خلال الحمية ال...
- 5 من فوائد فلفل الكايين الصحية المذهلة
- 7 من فوائد بذور الشيا الصحية للجسم
- أفضل 5 مشروبات تشربها على الإفطار
- «عائلة تس» في الرياض و«سوبر ماركت» الخميس
- متطوعون لإصلاح المركبات العالقة بالمطر
- ربى.. آلة تحول الكراتين التالفة لأكياس ورقية
- الاتحاد يواجه العين والجزيرة بمعسكر دبي
- منتخبنا يلعب بالأبيض.. ومناورة تجهزه لفيتنام
- جماهير الفورمولا 1 يتسابقون على حلبة كورني...
- الأردن يطالب بتحقيق للتأكد من جنس حارسة من...
- الأخضر لإحكام القبضة على الصدارة تفوق تاري...
- رينارد: علينا مضاعفة الجهد لتحقيق هدفنا
- المالكي: مبارياتنا المتبقية أشبه بالنهائيات
- وسائل إعلام: توقيف شخص في تركيا يشتبه بضلو...
- نوعان من الأطعمة "الصحية" تحتاج إلى تجنبهم...


